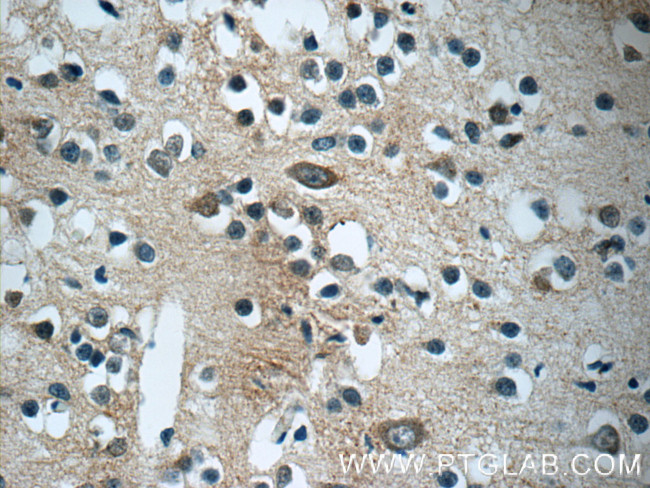
CaMKII beta Antibody in Immunohistochemistry (Paraffin) (IHC (P))

Search
Proteintech
CaMKII beta Polyclonal Antibody
{{$productOrderCtrl.translations['antibody.pdp.commerceCard.promotion.promotions']}}
{{$productOrderCtrl.translations['antibody.pdp.commerceCard.promotion.viewpromo']}}
{{$productOrderCtrl.translations['antibody.pdp.commerceCard.promotion.promocode']}}: {{promo.promoCode}} {{promo.promoTitle}} {{promo.promoDescription}}. {{$productOrderCtrl.translations['antibody.pdp.commerceCard.promotion.learnmore']}}
产品信息
11533-1-AP
种属反应
已发表种属
宿主/亚型
分类
类型
抗原
偶联物
形式
浓度
规格
纯化类型
保存液
内含物
保存条件
运输条件
产品详细信息
Immunogen sequence: MATTVTCTR FTDEYQLYED IGKGAFSVVR RCVKLCTGHE YAAKIINTKK LSARDHQKLE REARICRLLK HSNIVRLHDS ISEEGFHYLV FDLVTGGELF EDIVAREYYS EADASHCIQQ ILEAVLHCHQ MGVVHRDLKP ENLLLASKCK GAAVKLADFG LAIEVQGDQQ AWFGFAGTPG YLSPEVLRKE AYGKPVDIWA CGVILYILLV GYPPFWDEDQ HKLYQQIKAG AYDFPSPEWD TVTPEAKNLI NQMLTINPAK RITAHEALKH PWVCQRSTVA SMMHRQETVE CLKKFNARRK LKGAILTTML ATRNFS (1-315 aa encoded by B C019070)
靶标信息
CAMK2B (CaMKII beta) is a serine/threonine kinase that plays a role in synaptic plasticity, synaptic vesicle mobilization and regulation of gene expression. As a dominant kinase in the central nervous system it may function in long term potentiation and neurotransmitter release. There are four CaMKII isozymes, designated alpha, beta, gamma and delta, which may or may not be co-expressed in the same tissue type. CaMKII alpha is autophosphorylated on Thr 286 upon the binding of the Ca2+/CaM complex to the autoinhibitory domain of CaMKII. This process is called Ca2+/CaM trapping, which is thought to be involved in the synaptic encoding of information.
仅用于科研。不用于诊断过程。未经明确授权不得转售。
生物信息学
蛋白别名: alternatively spliced; Ca++/calmodulin-dependent protein kinase II beta subunit; Calcium, calmodulin-dependent protein kinase II; calcium/calmodulin-dependent protein kinase (CaM kinase) II beta; calcium/calmodulin-dependent protein kinase type II beta chain; Calcium/calmodulin-dependent protein kinase type II subunit beta; CaM kinase II beta subunit; CaM kinase II subunit beta; CaM-kinase II beta chain; CaMK II; caMK-II subunit beta; MGC29528; proline rich calmodulin-dependent protein kinase; protein kinase homolog; unnamed protein product; β CaMKII; βCaMKII
基因别名: CAM2; CAMK2; CAMK2B; Camk2d; CAMKB; CaMKIIbeta; Ck2b; MRD54
UniProt ID: (Human) Q13554, (Rat) P08413, (Mouse) P28652
Entrez Gene ID: (Human) 816, (Rat) 24245, (Mouse) 12323